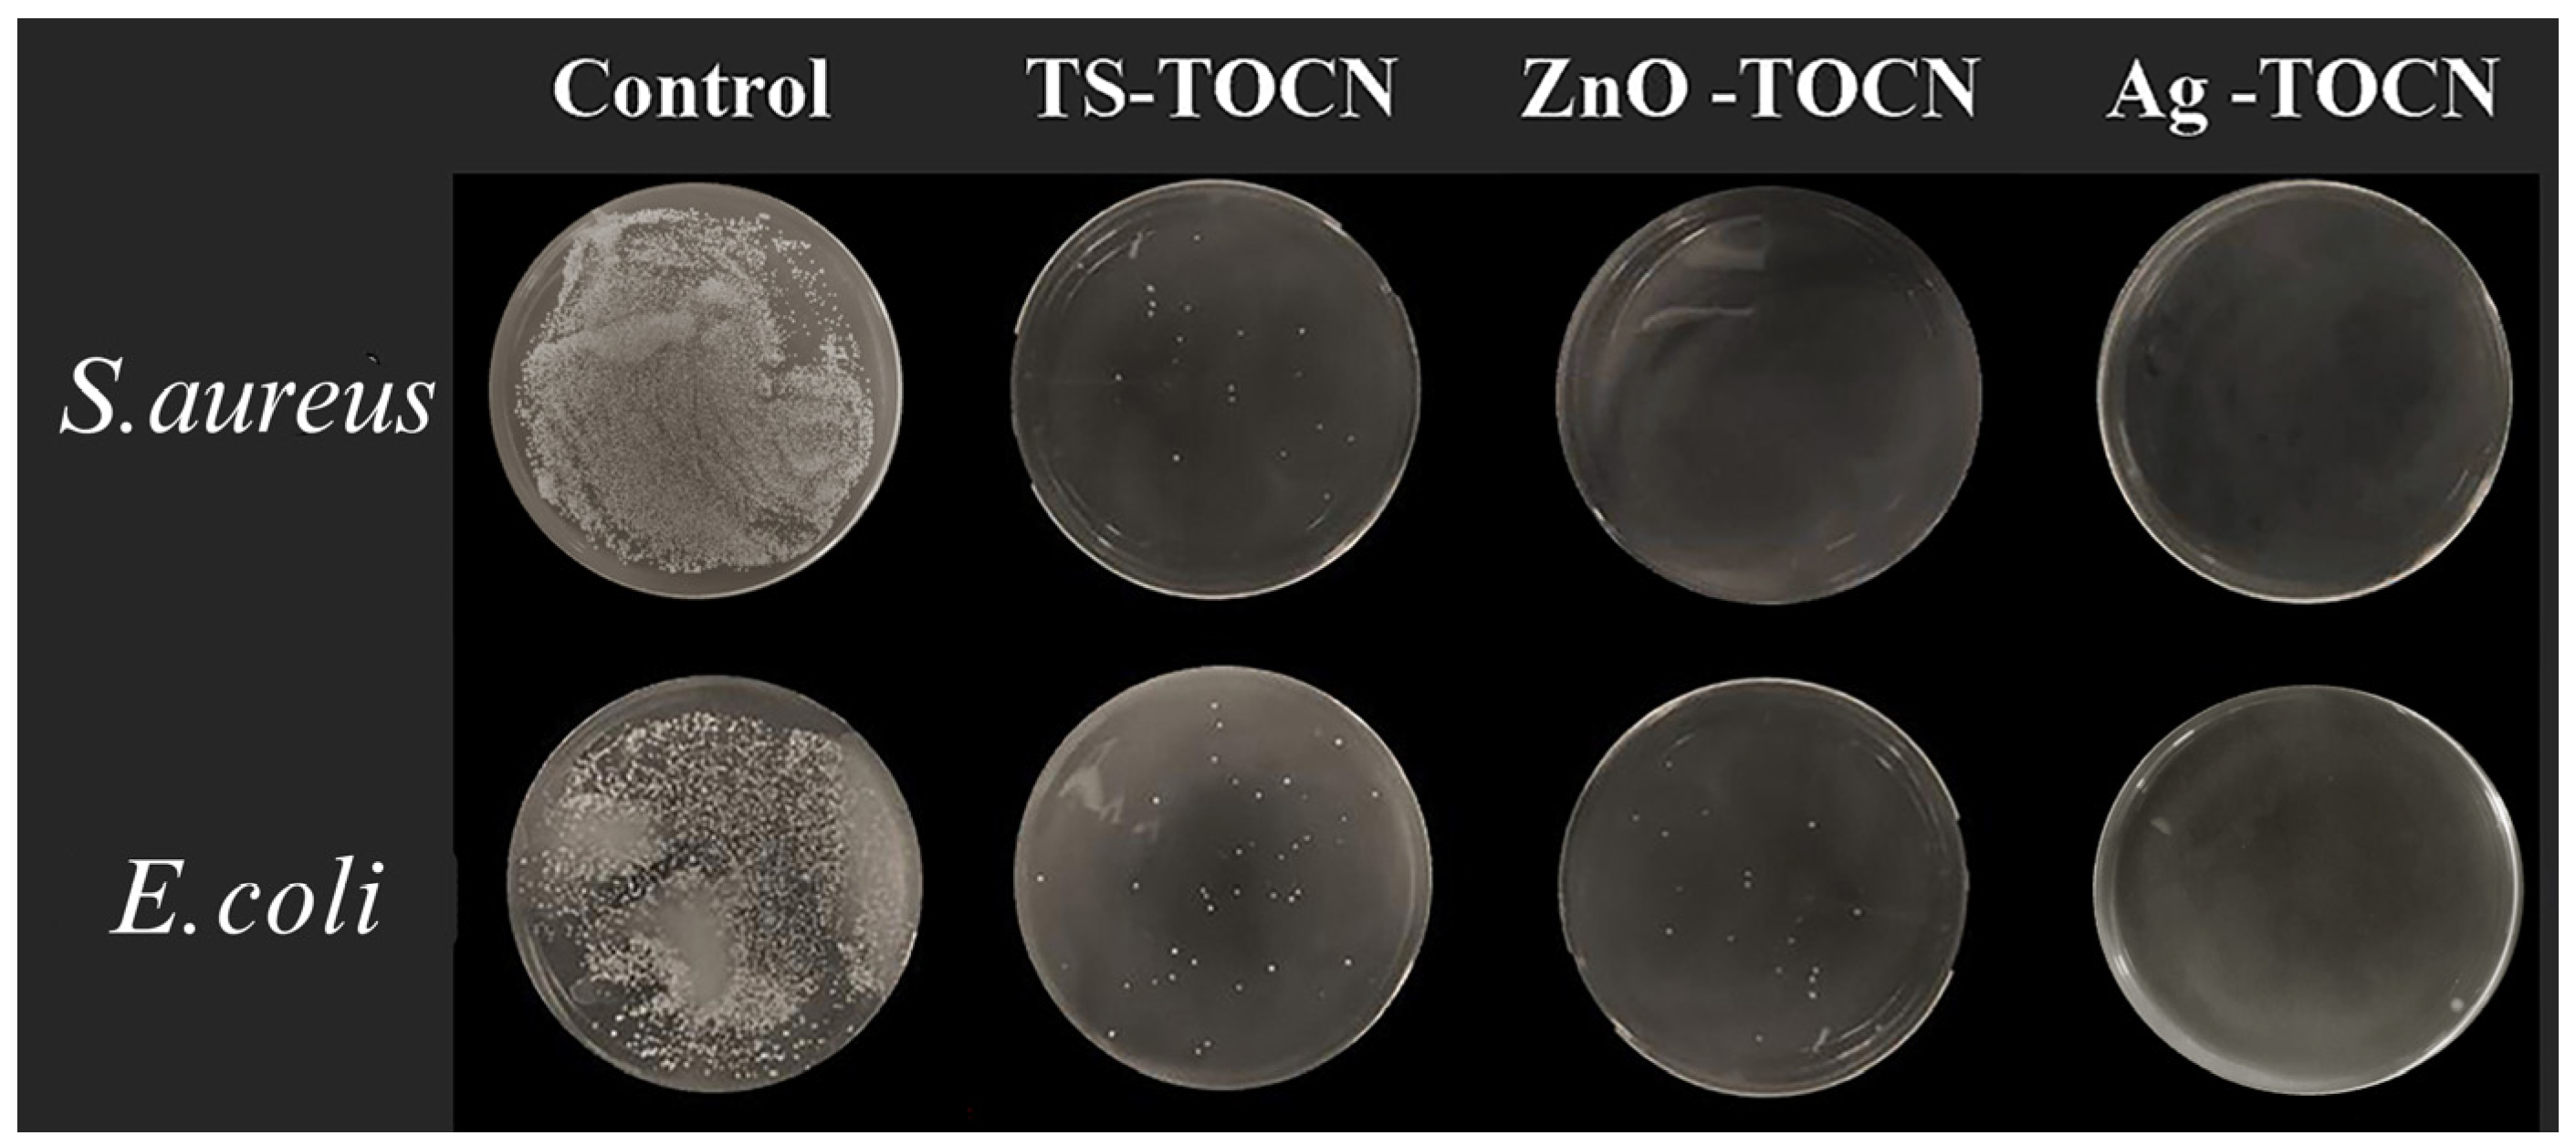
Polymers 16 01016 g007

TEMPO-Oxidized Nanocellulose Films Modified by Tea Saponin Derived from Camellia oleifera: Physicochemical, Mechanical, and Antibacterial Properties
Abstract
1. Introduction
2. Materials and Methods
2.1. Materials
2.2. Pretreatment Method
2.2.1. Preparation of Cellulose
2.2.2. Preparation of TOCNs
2.2.3. Preparation of TOCN Film
2.2.4. Preparation of TS-TOCN Film
2.3. Performance Testing and Characterization
2.3.1. Sample Morphology Observation
2.3.2. X-ray Diffraction (XRD)
2.3.3. Determination of Carboxyl in TOCN-x
2.3.4. Fourier-Transform Infrared Spectroscopy (FT-IR)
2.3.5. Tensile Test
2.3.6. Antibacterial Activity Testing
2.3.7. Oxygen Permeability Analysis
2.3.8. Antioxidant Property Analysis
3. Results and Discussion
3.1. Chemical Composition of Celluloses
3.2. Surface Morphology Analysis
3.3. XRD Analysis
3.4. Effect of Carboxyl Group Content on Cellulose
3.5. FT-IR Analysis
3.6. Mechanical Property Analysis
3.7. Antibacterial Analysis
3.8. Oxygen Barrier Properties
3.9. Antioxidant Analysis
4. Conclusions
Author Contributions
Funding
Institutional Review Board Statement
Data Availability Statement
Acknowledgments
Conflicts of Interest
References
- Zhao, X.; Cornish, K.; Vodovotz, Y. Narrowing the Gap for Bioplastic Use in Food Packaging: An Update. Environ Sci Technol. 2020, 54, 4712–4732. [Google Scholar] [CrossRef]
- Yadav, S.; Mehrotra, G.K.; Dutta, P.K. Chitosan Based Zno Nanoparticles Loaded Gallic-Acid Films for Active Food Packaging. Food Chem. 2021, 334, 127605. [Google Scholar] [CrossRef]
- Shen, F.; Xiong, X.; Fu, J.; Yang, J.; Qiu, M.; Qi, X.; Tsang, D.C.W. Recent Advances in Mechanochemical Production of Chemicals and Carbon Materials from Sustainable Biomass Resources. Renew. Sustain. Energ Rev. 2020, 130, 109944. [Google Scholar] [CrossRef]
- Ji, C.; Nguyen, L.N.; Hou, J.; Hai, F.I.; Chen, V. Direct Immobilization of Laccase on Titania Nanoparticles from Crude Enzyme Extracts of P. Ostreatus Culture for Micro-Pollutant Degradation. Sep. Purif. Technol. 2017, 178, 215–223. [Google Scholar] [CrossRef]
- Ahmad Alyosef, H.; Schneider, D.; Wassersleben, S.; Roggendorf, H.; Weiß, M.; Eilert, A. Meso/Macroporous Silica from Miscanthus, Cereal Remnant Pellets and Wheat Straw. ACS Sustain. Chem. Eng. 2015, 3, 2012–2021. [Google Scholar] [CrossRef]
- Douard, L.; Belgacem, M.N.; Bras, J. Extraction of Carboxylated Nanocellulose by Combining Mechanochemistry and Nades. ACS Sustain. Chem. Eng. 2022, 10, 13017–13025. [Google Scholar] [CrossRef]
- Bansal, M.; Kumar, D.; Chauhan, G.S.; Kaushik, A.; Kaur, G. Functionalization of Nanocellulose to Quaternized Nanocellulose Tri-Iodide and Its Evaluation as an Antimicrobial Agent. Int. J. Biol. Macromol. 2021, 190, 1007–1014. [Google Scholar] [CrossRef]
- Sharma, C.; Bhardwaj, N.K. Fabrication of Natural-Origin Antibacterial Nanocellulose Films Using Bio-Extracts for Potential Use in Biomedical Industry. Int. J. Biol. Macromol. 2020, 145, 914–925. [Google Scholar] [CrossRef] [PubMed]
- Hsu, H.H.; Khosrozadeh, A.; Li, B.; Luo, G.; Xing, M.; Zhong, W. An Eco-Friendly, Nanocellulose/Rgo/in Situ Formed Polyaniline for Flexible and Free-Standing Supercapacitors. ACS Sustain. Chem. Eng. 2019, 7, 4766–4776. [Google Scholar] [CrossRef]
- Jiang, Q.; Kacica, C.; Soundappan, T.; Liu, K.-k.; Tadepalli, S.; Biswas, P.; Singamaneni, S. An in Situ Grown Bacterial Nanocellulose/Graphene Oxide Composite for Flexible Supercapacitors. J Mater. Chem. A 2017, 5, 13976–13982. [Google Scholar] [CrossRef]
- Maliha, M.; Herdman, M.; Brammananth, R.; McDonald, M.; Coppel, R.; Werrett, M.; Andrews, P.; Batchelor, W. Bismuth Phosphinate Incorporated Nanocellulose Sheets with Antimicrobial and Barrier Properties for Packaging Applications. J. Clean. Prod. 2020, 246, 119016. [Google Scholar] [CrossRef]
- Adel, A.M.; Ibrahim, A.A.; El-Shafei, A.M.; Al-Shemy, M.T. Inclusion Complex of Clove Oil with Chitosan/Β-Cyclodextrin Citrate/Oxidized Nanocellulose Biocomposite for Active Food Packaging. Food Packaging. Shelf Life 2019, 20, 100307. [Google Scholar] [CrossRef]
- Frank, B.P.; Smith, C.; Caudill, E.R.; Lankone, R.S.; Carlin, K.; Benware, S.; Pedersen, J.A.; Fairbrother, D.H. Biodegradation of Functionalized Nanocellulose. Environ. Sci. Technol. 2021, 55, 10744–10757. [Google Scholar] [CrossRef] [PubMed]
- Liu, J.; Morales-Narváez, E.; Vicent, T.; Merkoçi, A.; Zhong, G.-H. Microorganism-Decorated Nanocellulose for Efficient Diuron Removal. Chem. Eng. J. 2018, 354, 1083–1091. [Google Scholar] [CrossRef]
- Claramunt, J.; Ventura, H.; Toledo Filho, R.D.; Ardanuy, M. Effect of Nanocelluloses on the Microstructure and Mechanical Performance of Cac Cementitious Matrices. Cem. Concr. Res. 2019, 119, 64–76. [Google Scholar] [CrossRef]
- Han, Q.; Gao, X.; Zhang, H.; Chen, K.; Peng, L.; Jia, Q. Preparation and Comparative Assessment of Regenerated Cellulose Films from Corn (Zea mays) Stalk Pulp Fines in Dmac/Licl Solution. Carbohydr. Polym. 2019, 218, 315–323. [Google Scholar] [CrossRef] [PubMed]
- Röder, T.; Morgenstern, B.; Schelosky, N.; Glatter, O. Solutions of cellulose in N, N-dimethylacetamide/lithium chloride studied by light scattering methods. Polymer 2001, 42, 6765–6773. [Google Scholar] [CrossRef]
- Onkarappa, H.S.; Prakash, G.K.; Pujar, G.H.; Rajith Kumar, C.R.; Latha, M.S.; Betageri, V.S. Hevea Brasiliensis Mediated Synthesis of Nanocellulose: Effect of Preparation Methods on Morphology and Properties. Int. J. Biol. Macromol. 2020, 160, 1021–1028. [Google Scholar] [CrossRef] [PubMed]
- Hu, S.; Gu, J.; Jiang, F.; Hsieh, Y.-L. Holistic Rice Straw Nanocellulose and Hemicelluloses/Lignin Composite Films. ACS Sustain. Chem. Eng. 2016, 4, 728–737. [Google Scholar] [CrossRef]
- Liu, C.; Li, B.; Du, H.; Lv, D.; Zhang, Y.; Yu, G.; Mu, X.; Peng, H. Properties of Nanocellulose Isolated from Corncob Residue Using Sulfuric Acid, Formic Acid, Oxidative and Mechanical Methods. Carbohydr. Polym. 2016, 151, 716–724. [Google Scholar] [CrossRef]
- Isogai, A.; Zhou, Y. Diverse Nanocelluloses Prepared from Tempo-Oxidized Wood Cellulose Fibers: Nanonetworks, Nanofibers, and Nanocrystals. Curr. Opin. Solid State Mater. 2019, 23, 101–106. [Google Scholar] [CrossRef]
- Wu, B.; Geng, B.; Chen, Y.; Liu, H.; Li, G.; Wu, Q. Preparation and Characteristics of Tempo-Oxidized Cellulose Nanofibrils from Bamboo Pulp and Their Oxygen-Barrier Application in Pla Films. Front. Chem. Sci. Eng. 2017, 11, 554–563. [Google Scholar] [CrossRef]
- Kaffashsaie, E.; Yousefi, H.; Nishino, T.; Matsumoto, T.; Mashkour, M.; Madhoushi, M.; Kawaguchi, H. Direct Conversion of Raw Wood to Tempo-Oxidized Cellulose Nanofibers. Carbohydr. Polym. 2021, 262, 117938. [Google Scholar] [CrossRef] [PubMed]
- Savarino, P.; Demeyer, M.; Decroo, C.; Colson, E.; Gerbaux, P. Mass Spectrometry Analysis of Saponins. Mass Spectrom. Rev. 2023, 42, 954–983. [Google Scholar] [CrossRef] [PubMed]
- Tang, Y.; He, X.; Sun, J.; Liu, G.; Li, C.; Li, L.; Sheng, J.; Zhou, Z.; Xin, M.; Ling, D.; et al. Comprehensive Evaluation on Tailor-Made Deep Eutectic Solvents (Dess) in Extracting Tea Saponins from Seed Pomace of Camellia oleifera Abel. Food Chem. 2021, 342, 128243. [Google Scholar] [CrossRef] [PubMed]
- Kołodzieja, B.; Sęczyka, Ł.; Sugiera, D.; Kędziab, B.; Chernetskyyc, M.; Gevrenovad, R.; Henrye, M. Determination of the Yield, Saponin Content and Profile, Antimicrobial and Antioxidant Activities of Three Gypsophila Species. Ind. Crop Prod. 2019, 138, 111422. [Google Scholar] [CrossRef]
- Tippel, J.; Gies, K.; Harbaum-Piayda, B.; Steffen-Heins, A.; Drusch, S. Composition of Quillaja Saponin Extract Affects Lipid Oxidation in Oil-in-Water Emulsions. Food Chem. 2017, 221, 386–394. [Google Scholar] [CrossRef] [PubMed]
- Wei, M.P.; Yu, H.; Guo, Y.H.; Cheng, Y.L.; Xie, Y.F.; Yao, W.R. Antibacterial Activity of Sapindus Saponins against Microorganisms Related to Food Hygiene and the Synergistic Action Mode of Sapindoside a and B against Micrococcus Luteus in Vitro. Food Control 2021, 130, 108337. [Google Scholar] [CrossRef]
- Orczyk, M.; Wojciechowski, K.; Brezesinski, G. The Influence of Steroidal and Triterpenoid Saponins on Monolayer Models of the Outer Leaflets of Human Erythrocytes, E. coli and S. cerevisiae Cell Membranes. J. Colloid Interface Sci. 2020, 563, 207–217. [Google Scholar] [CrossRef]
- Wang, D.; Huo, R.; Cui, C.; Gao, Q.; Zong, J.; Wang, Y.; Sun, Y.; Hou, R. Anticancer Activity and Mechanism of Total Saponins from the Residual Seed Cake of Camellia oleifera Abel. In Hepatoma-22 Tumor-Bearing Mice. Food Funct. 2019, 10, 2480–2490. [Google Scholar] [CrossRef]
- Qi, W.; Zhu, F.; Wang, M.; Teng, Z.; Xu, R.; Xi, Y.; Meng, Q.; Wu, X.; Zhao, H.; Ma, M.; et al. The Antitumoral Effect of Paris Saponin Ii on Head and Neck Squamous Cell Carcinomas Mediated Via the Nitric Oxide Metabolic Pathway. Front. Cell Dev. Biol. 2021, 9, 803981. [Google Scholar] [CrossRef] [PubMed]
- Shi, Q.; Jin, S.; Xiang, X.; Tian, J.; Huang, R.; Li, S.; Chen, C.; Xu, H.; Song, C. The Metabolic Change in Serum Lysoglycerophospholipids Intervened by Triterpenoid Saponins from Kuding Tea on Hyperlipidemic Mice. Food Funct. 2019, 10, 7782–7792. [Google Scholar] [CrossRef] [PubMed]
- Avato, P.; Bucci, R.; Tava, A.; Vitali, C.; Rosato, A.; Bialy, Z.; Jurzysta, M. Antimicrobial Activity of Saponins from Medicago sp.: Structure-Activity Relationship. Phytother. Res. 2006, 20, 454–457. [Google Scholar] [CrossRef] [PubMed]
- Shang, F.; Wang, H.; Xue, T. Anti-Biofilm Effect of Tea Saponin on a Streptococcus agalactiae Strain Isolated from Bovine Mastitis. Animals 2020, 10, 1713. [Google Scholar] [CrossRef]
- Luo, F.; Zeng, D.; Chen, R.; Zafar, A.; Weng, L.; Wang, W.; Tian, Y.; Hasan, M.; Shu, X. Pegylated Dihydromyricetin-Loaded Nanoliposomes Coated with Tea Saponin Inhibit Bacterial Oxidative Respiration and Energy Metabolism. Food Funct. 2021, 12, 9007–9017. [Google Scholar] [CrossRef] [PubMed]
- Wu, Z.; Tan, X.; Zhou, J.; Yuan, J.; Yang, G.; Li, Z.; Long, H.; Yi, Y.; Lv, C.; Zeng, C.; et al. Discovery of New Triterpenoids Extracted from Camellia oleifera Seed Cake and the Molecular Mechanism Underlying Their Antitumor Activity. Antioxidants 2023, 12, 7. [Google Scholar] [CrossRef] [PubMed]
- Long, H.; Gu, J.; Jiang, J.; Guan, L.; Lin, X.; Zhang, W.; Hu, C. Mechanically strong and biodegradable holocellulose films prepared from Camellia oleifera shells. Carbohydr. Polym. 2023, 299, 120189. [Google Scholar] [CrossRef]
- Yao, J.; Li, Z.; Shi, H.; Zeng, G.; Zhu, H. Seperation of Cellulose Nanocrystals Isolated from Fruit Shell of Camellia oleifera Abel and Their Film-forming Property. Fine Chem. 2018, 35, 1853–1858. [Google Scholar]
- Ortega-Nieto, C.; Losada-Garcia, N.; Prodan, D.; Furtos, G.; Palomo, J.M. Recent Advances on the Design and Applications of Antimicrobial Nanomaterials. Nanomaterials. 2023, 13, 2406. [Google Scholar] [CrossRef]
- Rajeshkumar, S.; Yadav, K.; Sridharan, M.; Roopan, S.M. Nano Silver: An Overview of Shape, Size-Controlled Synthesis and Their Antibacterial Property. High Energy Chem. 2023, 57, 205–216. [Google Scholar] [CrossRef]
- Müller, K.; Scheuerer, Z.; Florian, V.; Skutschik, T.; Sängerlaub, S. Comparison of test methods for oxygen permeability: Optical method versus carrier gas method. Polym Test. 2017, 63, 126–132. [Google Scholar] [CrossRef]
- ASTM D3985; Standard Test Method for Oxygen Gas Transmission Rate through Plastic Film and Sheeting Using a Coulometric Sensor. ASTM International: West Conshohocken, PA, USA, 2017; pp. 1–6.
- Ishii, D.; Tatsumi, D.; Matsumoto, T. Effect of solvent exchange on the supramolecular structure, the molecular mobility and the dissolution behavior of cellulose in LiCl/DMAc. Carbohydr. Res. 2008, 343, 919–928. [Google Scholar] [CrossRef] [PubMed]
- Li, W.; Zhang, F.; Wang, W.; Li, Y.; Liu, Y.; Lu, C.; Zhang, Z. Rheological Transitions and in-Situ Ir Characterizations of Cellulose/Licl·Dmac Solution as a Function of Temperature. Cellulose 2018, 25, 4955–4968. [Google Scholar] [CrossRef]
- Ye, W.; Hu, Y.; Ma, H.; Liu, L.; Yu, J.; Fan, Y. Comparison of Cast Films and Hydrogels Based on Chitin Nanofibers Prepared Using Tempo/Nabr/Naclo and Tempo/Naclo/Naclo(2) Systems. Carbohydr. Polym. 2020, 237, 116125. [Google Scholar] [CrossRef]
- Hu, Y.; Acharya, S.; Abidi, N. Cellulose Porosity Improves Its Dissolution by Facilitating Solvent Diffusion. Int. J. Biol. Macromol. 2019, 123, 1289–1296. [Google Scholar] [CrossRef]
- Hassan, S.H.; Velayutham, T.S.; Chen, Y.W.; Lee, H.V. Tempo-Oxidized Nanocellulose Films Derived from Coconut Residues: Physicochemical, Mechanical and Electrical Properties. Int. J. Biol. Macromol. 2021, 180, 392–402. [Google Scholar] [CrossRef] [PubMed]
- Tang, Z.; Li, W.; Lin, X.; Xiao, H.; Miao, Q.; Huang, L.; Chen, L.; Wu, H. Tempo-Oxidized Cellulose with High Degree of Oxidation. Polymers 2017, 9, 421. [Google Scholar] [CrossRef] [PubMed]
- Wu, C.; Zhang, X.; Wang, X.; Gao, Q.; Li, X. Surface modification of cellulose nanocrystal using succinic anhydride and its effects on poly (butylene succinate) based composites. Cellulose 2019, 26, 3167–3181. [Google Scholar] [CrossRef]
- Wakabayashi, M.; Fujisawa, S.; Saito, T.; Isogai, A. Nanocellulose Film Properties Tunable by Controlling Degree of Fibrillation of Tempo-Oxidized Cellulose. Front. Chem. 2020, 8, 37. [Google Scholar] [CrossRef]
- Zinge, C.; Kandasubramanian, B. Nanocellulose Based Biodegradable Polymers. Eur. Polym. J. 2020, 133, 109758. [Google Scholar] [CrossRef]
- Zhao, Y.; Su, R.; Zhang, W.; Yao, G.-L.; Chen, J. Antibacterial Activity of Tea Saponin from Camellia oleifera Shell by Novel Extraction Method. Ind. Crop Prod. 2020, 153, 112604. [Google Scholar] [CrossRef]
- Dong, S.; Yang, X.; Zhao, L.; Zhang, F.; Hou, Z.; Xue, P. Antibacterial Activity and Mechanism of Action Saponins from Chenopodium quinoa Willd. Husks against Foodborne Pathogenic Bacteria. Ind. Crop Prod. 2020, 149, 112350. [Google Scholar] [CrossRef]
- Sanchez-Gutierrez, M.; Bascon-Villegas, I.; Espinosa, E.; Carrasco, E.; Perez-Rodriguez, F.; Rodriguez, A. Cellulose Nanofibers from Olive Tree Pruning as Food Packaging Additive of a Biodegradable Film. Foods 2021, 10, 1584. [Google Scholar] [CrossRef] [PubMed]
- Fukuzumi, H.; Saito, T.; Iwamoto, S.; Kumamoto, Y.; Ohdaira, T.; Suzuki, R.; Isogai, A. Pore Size Determination of Tempo-Oxidized Cellulose Nanofibril Films by Positron Annihilation Lifetime Spectroscopy. Biomacromolecules 2011, 12, 4057–4062. [Google Scholar] [CrossRef] [PubMed]
- Chagnoleau, J.B.; Ferreira, A.M.; Coutinho, J.A.P.; Fernandez, X.; Azoulay, S.; Papaiconomou, N. Sustainable Extraction of Antioxidants from out-of-Caliber Kiwifruits. Food Chem. 2023, 401, 133992. [Google Scholar] [CrossRef] [PubMed]
- Sedaghat Doost, A.; Van Camp, J.; Dewettinck, K.; Van der Meeren, P. Production of Thymol Nanoemulsions Stabilized Using Quillaja Saponin as a Biosurfactant: Antioxidant Activity Enhancement. Food Chem. 2019, 293, 134–143. [Google Scholar] [CrossRef]
- Oyeleke, M.B.; Owoyele, B.V. Saponins and Flavonoids from Bacopa floribunda Plant Extract Exhibit Antioxidant and Anti-Inflammatory Effects on Amyloid Beta 1-42-Induced Alzheimer’s Disease in Balb/C Mice. J. Ethnopharmacol. 2022, 288, 114997. [Google Scholar] [CrossRef]

| Camellia oleifera Fruit Shell | Camellia oleifera Fruit Shell Cellulose | DMAc/LiCl-Treated Cellulose | ||||
|---|---|---|---|---|---|---|
| 3 wt% | 5 wt% | 7 wt% | 9 wt% | |||
| Cellulose % | 19.2 ± 0.21 | 84.3 ± 0.67 | 87.0 ± 0.32 | 96.7 ± 0.12 | 95.0 ± 0.43 | 96.0 ± 0.52 |
| Hemicellulose % | 28.6 ± 0.65 | 7.3 ± 0.25 | 5.3 ± 0.25 | - | - | - |
| Holocellulose % | 47.9 ± 0.33 | - | - | - | - | - |
| Lignin % | 29.1 ± 0.23 | 3.9 ± 0.30 | 2.8 ± 0.61 | 0.7 ± 0.48 | - | - |
| Ash % | 3.2 ± 0.31 | 1.2 ± 0.45 | - | - | - | - |
| Extractive % | 19.7 ± 0.69 | ND | ND | ND | ND | ND |
| Sample | TOCN-0 | TOCN-3 | TOCN-5 | TOCN-7 | TOCN-9 |
|---|---|---|---|---|---|
| Concentration of DMAc/LiCl (wt%) | 0 | 3% | 5% | 7% | 9% |
| -COOH content (meq/100 g) | 160 | 210 | 272 | 326 | 378 |
| TOCN-0 | TOCN-3 | TOCN-5 | TOCN-7 | TOCN-9 | |
|---|---|---|---|---|---|
| Tensile Stress/MPa | 34.99967 | 36.76179 | 48.15186 | 63.91672 | 34.39672 |
| Tensile Strain at Break/% | 3.57903 | 4.18075 | 4.74976 | 1.76351 | 1.80684 |
| Young’s Modulus/MPa | 2688 | 2559 | 3944 | 4588 | 1369 |
Disclaimer/Publisher’s Note: The statements, opinions and data contained in all publications are solely those of the individual author(s) and contributor(s) and not of MDPI and/or the editor(s). MDPI and/or the editor(s) disclaim responsibility for any injury to people or property resulting from any ideas, methods, instructions or products referred to in the content. |
© 2024 by the authors. Licensee MDPI, Basel, Switzerland. This article is an open access article distributed under the terms and conditions of the Creative Commons Attribution (CC BY) license (https://creativecommons.org/licenses/by/4.0/).
Share and Cite
Jiang, N.; Hu, Y.; Cheng, Y. TEMPO-Oxidized Nanocellulose Films Modified by Tea Saponin Derived from Camellia oleifera: Physicochemical, Mechanical, and Antibacterial Properties. Polymers 2024, 16, 1016. https://doi.org/10.3390/polym16071016
Jiang N, Hu Y, Cheng Y. TEMPO-Oxidized Nanocellulose Films Modified by Tea Saponin Derived from Camellia oleifera: Physicochemical, Mechanical, and Antibacterial Properties. Polymers. 2024; 16(7):1016. https://doi.org/10.3390/polym16071016
Chicago/Turabian StyleJiang, Nan, Yudi Hu, and Yuhang Cheng. 2024. "TEMPO-Oxidized Nanocellulose Films Modified by Tea Saponin Derived from Camellia oleifera: Physicochemical, Mechanical, and Antibacterial Properties" Polymers 16, no. 7: 1016. https://doi.org/10.3390/polym16071016
APA StyleJiang, N., Hu, Y., & Cheng, Y. (2024). TEMPO-Oxidized Nanocellulose Films Modified by Tea Saponin Derived from Camellia oleifera: Physicochemical, Mechanical, and Antibacterial Properties. Polymers, 16(7), 1016. https://doi.org/10.3390/polym16071016

